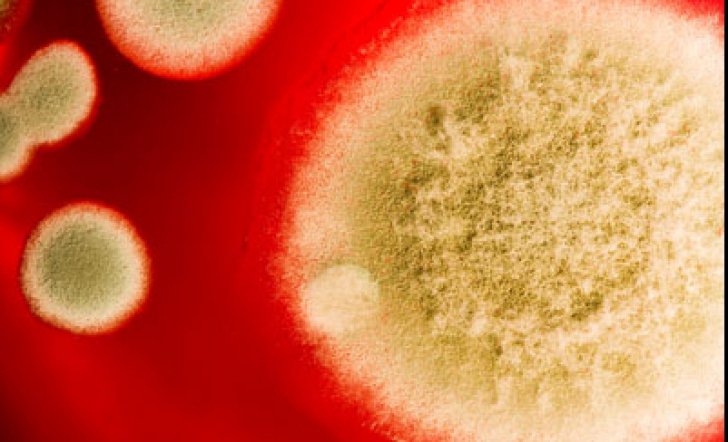

Infecția cu o ciupercă rară, numită de cercetători Candida Auris, a fost pentru prima dată identificată de doctorii japonezi în 2009, în urechea unui pacient, și de atunci a dus la închiderea multor spitale din întreaga lume și la multe decese.
Candida auris, o ciupercă, este germenul care se răspândeşte la nivel global şi reprezintă o ameninţare gravă la adresa sănătăţii publice deoarece ciuperca opune rezistenţă la medicamente, relatează publicaţia New York Times.
Potrivit studiilor, saşe din zece persoane infectate cu această superciupercă îşi pierd viaţa, deşi medicii nu au putut să demostreze fără nicio urmă de îndoială că această ciupercă cauzează direct moartea unor pacienţi.
În ultimii cinci ani, superciuperca a afectat o unitate neonatală din Venezuela, un spital din Spania, o unitate de terapie intensivă dintr-un spital de prestigiu din Marea Britanie, precum şi centre spitaliceşti din India, Pakistan şi Africa de Sud.
Recent, Candida auris a ajuns şi la New York, New Jersey şi Illinois, urmând ca Centrele Federale pentru Controlul şi Prevenirea Bolilor din SUA să ia măsuri şi să adauge ciuperca pe lista „ameninţărilor urgente”.
Timp de decenii, experţii în domeniul sănătăţii publice au avertizat că excesul de antibiotice reduce eficienţa medicamentelor care contribuie la prelungirea speranţei de viaţă prin vindecarea infecţiilor bacteriene care erau odata, în mod obişnuit, fatale.
Dar, în ultima vreme, a avut loc şi o explozie de fungi rezistenţi, adăugând o dimensiune nouă şi înfricoşătoare unui fenomen care subminează un pilon al medicinei moderne. Pur şi simplu, ciupercile, la fel ca bacteriile, dezvoltă rezistenţa pentru a supravieţui medicamentelor moderne, scrie Adevarul.ro
NEWS 2.0









